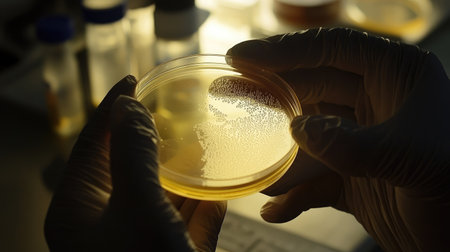
Close-up of gloved hands holding a petri dish, highlighting scientific research and care in a lab.の素材

素材 - Close-up of gloved hands holding a petri dish, highlighting scientific research and care in a lab.
作品情報
Close-up of gloved hands holding a petri dish, highlighting scientific research and care in a lab.
- ID:261364859
- 作品種別:
- 作者名:suphauarrn Manosri
キーワード
- accuracy
- analysis
- analyzing
- antibiotic
- bacterium
- biology
- biotechnology
- candy
- colourful
- copy space
- cut out
- design element
- dish
- dna
- equipment
- exam
- experiment
- expertise
- food
- glove
- hand
- handling
- health
- health care
- healthcare and medicine
- human hand
- hygiene
- illness
- innovation
- inspection
- laboratory
- medicine
- microbiology
- pharmacy
- precision
- research
- safety
- sample
- science
- scientific
- sterile
- study
- technician
- test
- testing
- white background
類似作品
handshake of a ...
Woman doctor is...
Female doctor b...
cropped view of...
Folded hands in...
A hand, with a ...
A hand pointing...
A person's arms...
Hands putting o...
Doctors in medi...
Two palms in pi...
Close-up view o...
Nurse or cosmet...
men wearing a y...
Doctors and nur...
Latex glove
Detail green sc...
yellow backgrou...
The doctor puts...
Closeup shot of...
Child girl show...
Profile side vi...
Religious catho...
Lifestyle conce...
Displaying Empt...
Monkey hands
Scientist hand ...
A healthcare wo...
Couple hugging
Profile side vi...
waiting musicia...
Close-up of sur...
Woman in blue m...
Hand in blue pr...
A pair of hands...
Hand in a white...
A close-up of h...
Close up of a d...
The doctor puts...
two female hand...
Medical glove w...
female doctor i...
Rubber Gloves i...
Close up hands ...
Closeup of prof...
A person wearin...
Shaking hands w...
Person wearing ...
Doctor in medic...